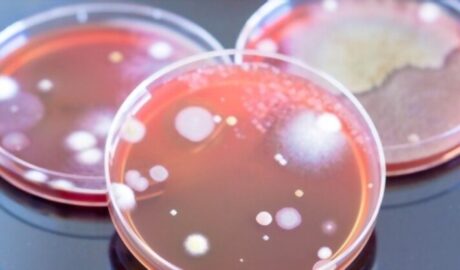
Micro Organisms

-
A b o u t - U s3000 years of Plant-Wellness
Re-defined || with Technological Research.To curate new dimensional solutions.
-
K n o w - M o r eBack Pain Relief Unlocked
Nature has No Limits.Experience the Wonders of Herbal Magic.
Natural Essential Oils
Discard chemicals and rejoice life naturally
Wide Spectrum Usage
Synthetics In Disguise
An all-time smart synthetics, could be difficult to escape
Your Skin & Our Promise
Purity and Safety
FTIR
It's used to ensure the potency and consistent quality of a batch of oil. This method identifies the structural components of essential oil compounds. And the quality is estd. referring to a pure quality historical database.
Chirality
This test ensures that no synthetic elements are present in the essential oil. It determines the 3D orientation of a molecule. Chiral molecules exist in 2-forms like our right & left hand, where their ratio determines the purity of oil.
Isotopes
It is used to detect the essential oil purity by determining the ratio of carbon atom isotopes, as to which isotopes are present in what amounts. Every constituent in the oil should have same ratio of isotopes to determine purity.